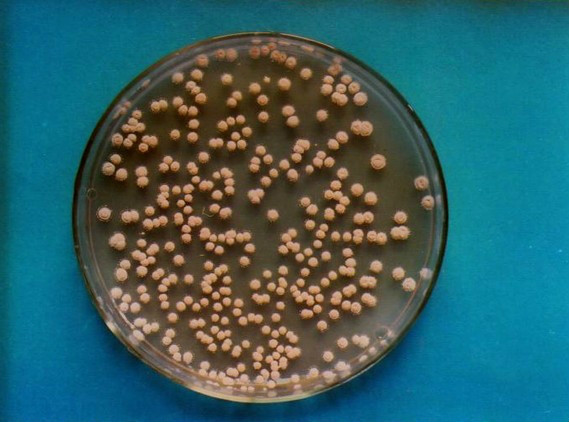
细黄链霉菌

链杆菌图片

链杆菌病
图片尺寸500x372
革兰染色:链杆状,球杆菌
图片尺寸476x438
图1-5 不同的杆菌.png
图片尺寸633x808
罗非鱼的真实情况养殖现状和食用安全分析
图片尺寸650x467
链杆菌病
图片尺寸300x236
p>链球菌是 a href="#" data-lemmaid="976251">化脓性球菌 /a>的另
图片尺寸1280x1182
链球菌照片
图片尺寸400x300
链球菌
图片尺寸450x600
变形链球菌丨wikimedia commons, centers for disease
图片尺寸550x402
结核杆菌(网络图)
图片尺寸600x407
请问这种乳酸杆菌排成一队像一个长的杆菌的情况学名如何称呼?
图片尺寸3456x4608
链球菌
图片尺寸600x450
灰色链霉菌成美新泽西州"州微生物"
图片尺寸720x540
苍金荣 链状念珠菌 转sda
图片尺寸977x971
细黄链霉菌
图片尺寸569x422
幽门螺杆菌感染是抽血检查好还是呼气检查准确医生告诉你心得
图片尺寸640x392
jem: t细胞抵抗寨卡病毒感染的机制
图片尺寸519x304
5.砧板上的大肠杆菌和链霉菌会导致肠道外感染,急性腹泻,肝炎等.
图片尺寸600x402
一种白色链霉菌x-18及利用该菌生产ε-聚赖氨酸的方法与流程
图片尺寸378x284
链球菌属
图片尺寸640x360